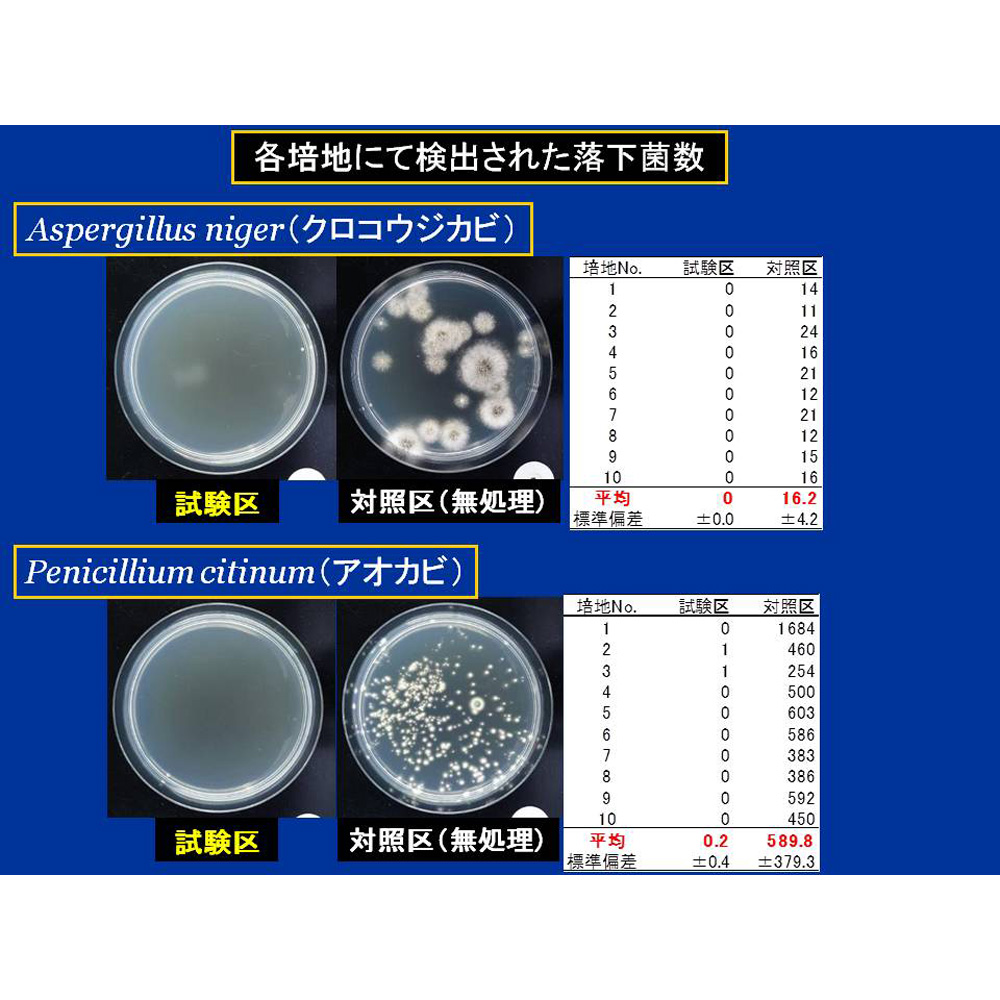

4/26
時点_ポイント最大3倍
安心空間 カビ阻止ジェット(ホワイトラベル) 1本 カビ取り剤 掃除 お手入れ用品 651478
販売価格
2,420
円 (税込)
- 出荷目安:
- 注文受付後2日~5日以内に発送予定
たまるdポイント(通常) 22
+キャンペーンポイント(期間・用途限定) 最大2倍
※たまるdポイントはポイント支払を除く商品代金(税抜)の1%です。
※表示倍率は各キャンペーンの適用条件を全て満たした場合の最大倍率です。
各キャンペーンの適用状況によっては、ポイントの進呈数・付与倍率が最大倍率より少なくなる場合がございます。
dカードでお支払ならポイント3倍
各キャンペーンの適用状況によっては、ポイントの進呈数・付与倍率が最大倍率より少なくなる場合がございます。
- 商品情報
- レビュー
【販売店・発送】株式会社dinos
【申込番号】651478
【商品基本コード】1245600279
ご注文ガイド
仕様・サイズ
【送料マーク:A】
■容量200ml
■無水エタノール 防カビ・抗菌剤(MIS) 噴射ガス(DME)
※濃色の素材に液剤がかかると白っぽくなる場合があります。
※3ヵ月に1回程度のご使用をおすすめします。(水のかからない箇所や環境によって効果の保持期間は異なります。)
※ガス検知器の近くで使用すると反応する場合がありますのでご注意ください。
■日本製
■無水エタノール 防カビ・抗菌剤(MIS) 噴射ガス(DME)
※濃色の素材に液剤がかかると白っぽくなる場合があります。
※3ヵ月に1回程度のご使用をおすすめします。(水のかからない箇所や環境によって効果の保持期間は異なります。)
※ガス検知器の近くで使用すると反応する場合がありますのでご注意ください。
■日本製
商品の説明
キッチンや子ども部屋など、いままでカビ取り剤を使うのをためらっていた場所にも、安心して使える防カビ・抗菌剤です。温泉でもおなじみのイオウ類や、うがいをするときにも使われるヨード類などを組み合わせた安全性の高い独自成分がカビを活動できない状況にさせます。肌に触れても問題のない成分は、食品工場や医療機関でも採用されています。
商品画像の説明。



湿気がこもりやすいクローゼットの中などにもOK!
エアコンを作動させながら使用すれば、エアコン内部の防カビ処理も同時に出来ます。
お風呂にもOK!安心空間でカビを防いでおけば、カビが発生しづらいので面倒なお掃除の心配もありません。
※自動車内部に使用する場合は運転席足下のエアコン吸気口に置き、外気を止めてエアコンを作動させながらご使用ください。
全量で12畳までのお部屋に対応。リビングも1本でまるごと処理できます。
※カビ阻止ジェットを使用した食パンと未使用の食パンの比較実験 ※メーカー調べ 試験環境下での結果であり、実使用環境での効果を保証するものではありません。
濾紙における Cladosporium の発育面積|(株)エフシージー総合研究所調べ
各培地にて検出された落下菌数|(株)エフシージー総合研究所調べ ※すべての菌に効果があるわけではありません。
※メーカー調べ 試験環境下での結果であり、実使用環境での効果を保証するものではありません。










